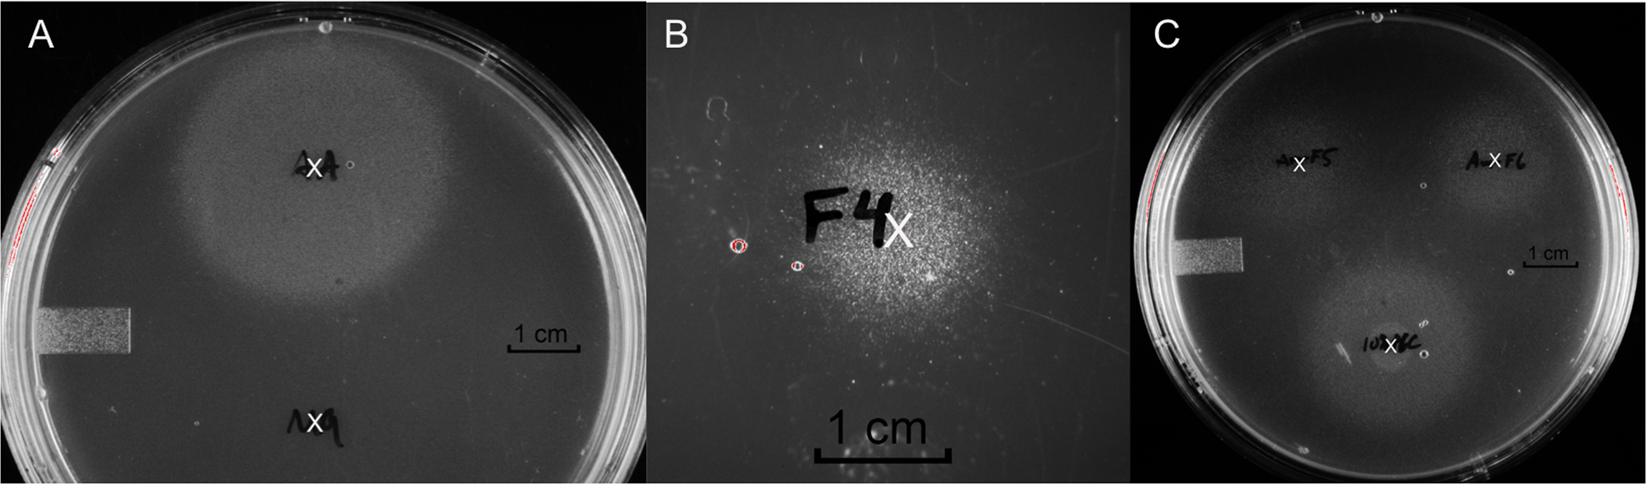
Figure 1

Figure 1
CFT073 in vitro quiescence assay. The location of spotting a sample is designated by the white ‘x’. (A)- tyrosine, lysine, and methionine positive control (Top) and M9 medium negative control (Bottom), (B)- uG3m2, (C)- Clockwise from bottom: cPOS, uG4m3 and HDP-cPOS.